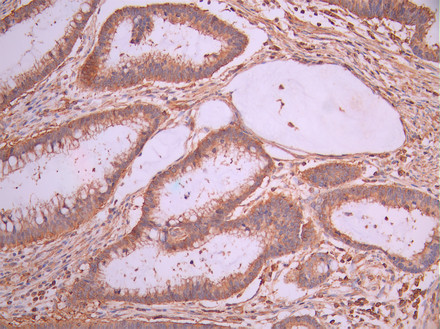

PDLIM1 Recombinant Monoclonal Antibody
-
中文名稱:PDLIM1 Recombinant Monoclonal Antibody
-
貨號:CSB-RA965164A0HU
-
規(guī)格:¥1320
-
圖片:
-
Western Blot
, Positive WB detected in:PC-3 whole cell lysate(30μg), A431 whole cell lysate(30μg)
All lanes: PDLIM1 antibody at 1:1000
Secondary
Goat polyclonal to rabbit IgG at 1/40000 dilution
Predicted band size: 36 kDa
Observed band size: 36 kDa
Exposure time:120s -
IHC image of CSB-RA965164A0HU diluted at 1:100 and staining in paraffin-embedded human gastric cancer performed on a Leica BondTM system. After dewaxing and hydration, antigen retrieval was mediated by high pressure in a citrate buffer (pH 6.0). Section was blocked with 10% normal goat serum 30min at RT. Then primary antibody (1% BSA) was incubated at 4°C overnight. The primary is detected by a Goat anti-rabbit polymer IgG labeled by HRP and visualized using 0.05% DAB.
-
Overlay Peak curve showing Hela cells stained with CSB-RA965164A0HU (red line) at 1:100. The cells were fixed in 4% formaldehyde and permeated by 0.2% TritonX-100 for 10min. Then 10% normal goat serum to block non-specific protein-protein interactions followed by the antibody (1ug/1*106cells) for 45min at 4℃. The secondary antibody used was FITC-conjugated goat anti-rabbit IgG (H+L) at 1/200 dilution for 35min at 4℃.Control antibody (green line) was Rabbit IgG (1ug/1*106cells) used under the same conditions. Acquisition of >10, 000 events was performed.
-
-
其他:
產(chǎn)品詳情
-
Uniprot No.:
-
基因名:PDLIM1
-
別名:C terminal LIM domain protein 1 antibody; C-terminal LIM domain protein 1 antibody; Carboxy terminal LIM domain protein 1 antibody; CLIM 1 antibody; CLIM1 antibody; CLP 36 antibody; CLP36 antibody; Elfin antibody; Enigma antibody; Enigma homolog antibody; hCLIM 1 antibody; hCLIM1 antibody; LIM domain protein CLP 36 antibody; LIM domain protein CLP-36 antibody; LIM domain protein CLP36 antibody; PDLI1_HUMAN antibody; PDLIM 1 antibody; Pdlim1 antibody; PDZ and LIM domain 1 antibody; PDZ and LIM domain protein 1 antibody
-
反應種屬:Human
-
免疫原:A synthesized peptide from human PDLIM1 protein
-
免疫原種屬:Homo sapiens (Human)
-
標記方式:Non-conjugated
-
克隆類型:Monoclonal
-
抗體亞型:Rabbit IgG
-
純化方式:Affinity-chromatography
-
克隆號:19E12
-
濃度:It differs from different batches. Please contact us to confirm it.
-
保存緩沖液:Rabbit IgG in 10mM phosphate buffered saline , pH 7.4, 150mM sodium chloride, 0.05% BSA, 0.02% sodium azide and 50% glycerol.
-
產(chǎn)品提供形式:Liquid
-
應用范圍:ELISA, WB, IHC, FC
-
推薦稀釋比:
Application Recommended Dilution WB 1:500-1:5000 IHC 1:50-1:200 FC 1:50-1:200 -
Protocols:
-
儲存條件:Upon receipt, store at -20°C or -80°C. Avoid repeated freeze.
-
貨期:Basically, we can dispatch the products out in 1-3 working days after receiving your orders. Delivery time maybe differs from different purchasing way or location, please kindly consult your local distributors for specific delivery time.
-
用途:For Research Use Only. Not for use in diagnostic or therapeutic procedures.
相關產(chǎn)品
靶點詳情
-
功能:Cytoskeletal protein that may act as an adapter that brings other proteins (like kinases) to the cytoskeleton. Involved in assembly, disassembly and directioning of stress fibers in fibroblasts. Required for the localization of ACTN1 and PALLD to stress fibers. Required for cell migration and in maintaining cell polarity of fibroblasts.
-
基因功能參考文獻:
- PDLIM1 was shown to interact with p75(NTR) in highly invasive patient-derived glioma stem cells/tumor-initiating cells and shRNA knockdown of PDLIM1 in vitro and in vivo results in complete ablation of p75(NTR)-mediated invasion. PMID: 26119933
- downregulation of PDLIM1 in colorectal cancer samples correlated with reduced E-cadherin and membrane beta-catenin levels PMID: 26701804
- Our results identify CLP36 as an important regulator of breast cancer cell migration and metastasis, and shed light on how increased CLP36 expression contributes to the progression of breast cancer. PMID: 24662836
- Femtomolar Zn2+ affinity of LIM domain of PDLIM1 protein uncovers crucial contribution of protein-protein interactions to protein stability. PMID: 22922308
- Robust co-regulation of tyrosine phosphorylation sites has been revealed on novel protein interactions between EGFR and PDLIM1. PMID: 22851037
- PDLIM1 showed moderate parent-of origin effects for some single nucleotide polymorphisms in attention deficit disorder with hyperactivity. PMID: 21651830
- Alpha-actinin-4 and CLP36 protein deficiencies contribute to podocyte defects in multiple human glomerulopathies PMID: 21680739
- results establish the CLP-36 PDZ-LIM protein as an adapter, recruiting the Clik1 kinase to actin stress fibers in nonmuscle cells, and suggest that Clik1 represents a novel regulator of actin stress fibers PMID: 11973348
- We present evidence for the exclusive protein expression of CLP36 in proliferative and early post-proliferative trophoblast cells. PMID: 16609848
- Enigma protein shown to interact with alpha actinin 2 by yeast two-hybrid screening and immunochemistry (co-localization at myocardial Z-disks). PMID: 10861853
- CLP-36 contains a PDZ- and LIM domain, is widely expressed, interacts with actinin-1, actinin-2 and actinin-4, and localizes to actin stress fibers. The gene (7 exons) is localised to contig NT_008878.2 on chromosome 10. PMID: 11110697
顯示更多
收起更多
-
亞細胞定位:Cytoplasm. Cytoplasm, cytoskeleton. Cytoplasm, myofibril, sarcomere, Z line.
-
組織特異性:Strongly expressed in the heart and skeletal muscle, moderately expressed in the spleen, small intestine, colon, placenta, and lung. A lower level expression is seen in liver, thymus, kidney, prostate and pancreas and is not found in the brain, testis, ov
-
數(shù)據(jù)庫鏈接:
Most popular with customers
-
-
YWHAB Recombinant Monoclonal Antibody
Applications: ELISA, WB, IHC, IF, FC
Species Reactivity: Human, Mouse, Rat
-
Phospho-YAP1 (S127) Recombinant Monoclonal Antibody
Applications: ELISA, WB, IHC
Species Reactivity: Human
-
-
-
-
-